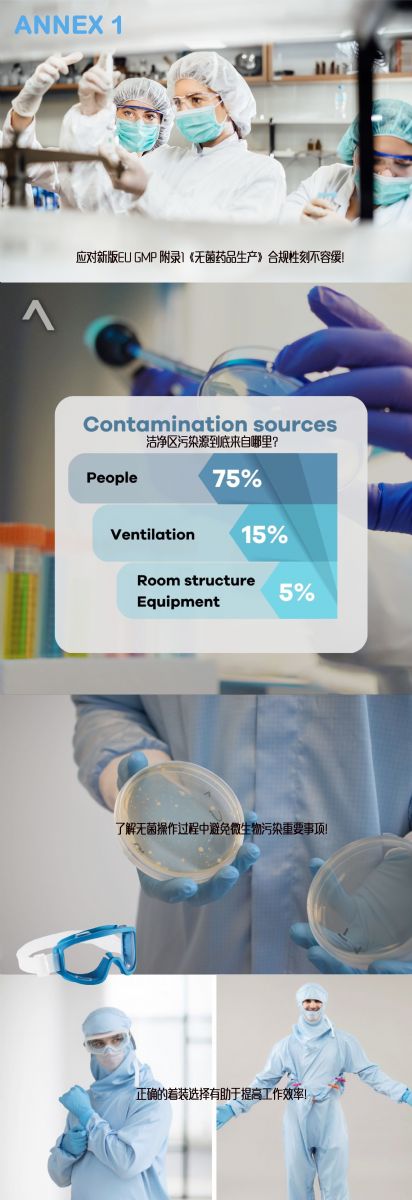

朗喜邀您參加藥品質量控制與檢驗技術創新實踐大會

允咨醫藥培訓中心攜手國內外質量檢驗領域最具經驗的實踐專家和法規專家,圍繞實驗室安全與合規管理、藥物分析檢測技術、及微生物控制等難點進行實例講解,共同探討藥品檢驗的最新理論、方法和實踐案例,分享檢驗技術的創新成果和應用經驗。
朗喜工業受邀參展本次研討會,與您一同探討應對藥品質量安全中應對微生物污染策略,朗喜展位:A02
- CGT Asia 第十屆亞洲細胞與基因治療創新峰會通知
- 禮智生物將亮相大灣區腦病中醫藥科創與產學研大會
- NEW-MED 2026生物材料研發及應用峰會通知
- 隱智科儀攜智能儀器解決方案亮相華人生物分析論壇
- 2026生物農藥研發創制與農藥制劑加工研討會通知
- 2026第八屆國際功能醫學創新大會通知
- CGLTS2025北京細胞與基因免疫治療亦莊峰會通知
- 第11屆全國植物生物學與植物逆境生物學研討會通知
- 2026作物高產高效栽培與生態耕作學術研討會通知
- 2026廣西臨床檢驗儀器、試劑與輸血用品展覽會通知
- 北京基爾比攜類器官科研儀器參加BSCB2025學術年會
- 華威中儀邀您參加2025全國海洋微生物學學術研討會
- CBIC 2026細胞生物產業大會邀請函
- 霍爾斯攜經典發酵罐及切向流超濾系統亮相BioONE2025
- 慧榮和亮相中國毒理學會農藥毒理學專委會成立大會
- 安升達凍存管現貨來襲,快來申請試用吧!
- 本生生物推出開學季熒光定量PCR耗材限時特惠活動
- 本生生物推出移液器吸頭滿一送一促銷活動
- 中檢維康推出新品IAC-SEP雙酚A/F/S三合一免疫親和柱
- 龍海化工招聘斥菌防霉塑料項目拓展經理
- 中檢維康生物推出新品IAC-SEP馬兜鈴酸免疫親和柱
- 賽瑞特國內工廠生產L86系列高壓滅菌袋重磅上線
- SpiroChrome SiR推出新品PKMEM™系列的細胞膜探針
- 諾杰成為美國領先潔凈室產品商Micronova授權銷售商
- BUNSEN本生推出:新學期特惠促銷活動
- 耐思一次性筆式注射器獲美國FDA 510(K)認證
- 潔特生物帶環螺旋蓋一次性凍存管嶄新上市
- 耐思直播:類器官計數分析軟件發布會
- NEST重復性筆式注射器獲批美國FDA 510(k) !
- 諾杰喜獲英國潔凈室制造商NXTCLEAN亞太地區代理權
Copyright(C) 1998-2025 生物器材網 電話:021-64166852;13621656896 E-mail:info@bio-equip.com







